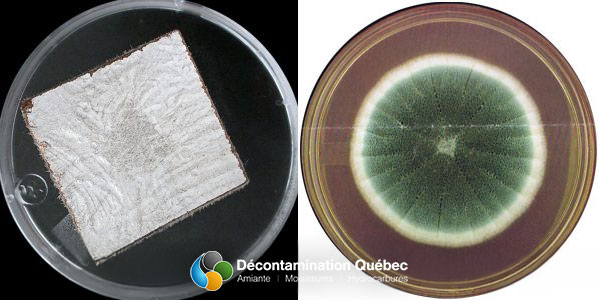
Décontamination Qc

L'Institut National de Santé Publique du Québec (INSPQ) a identifié en particulier trois espèces d’Aspergillus pouvant causer des problèmes de santé au Québec. Nous regardons plus en détails les trois espèces suivantes: Aspergillus fumigatus, Aspergillus flavus et Aspergillus niger.
Pour vous donner une idée générale de l’Aspergillus, c’est un mycète dont on dénombre plus de 200 espèces, dont 40 sont documentées comme étant une cause d’infection pour l’homme, selon l’INSPQ. On retrouve celle-ci dans les sols et la matière organique principalement. Cependant, elle peut se retrouver aussi dans l’eau et la nourriture.
La gamme de couleur varie selon l’espèce, les colonies peuvent être blanches, jaunes, vertes ou noires.
L’Aspergillus fumigatus est l’espèce la plus importante en ce qui attrait les problèmes de santé. Elle est associée à l’aspergillose, maladie pulmonaire qui est très opportuniste (nous en reparlerons tantôt). Présentement, vous pourriez avoir des spores Aspergillus dans les poumons sans le savoir car les défenses immunitaires du corps pourront l’éliminer. C’est pourquoi ces spores sont dit opportunistes, ils attendent que le système immunitaire faiblisse pour frapper.
De ce fait, les personnes immunodéprimées ou qui ont des troubles respiratoires sont vraiment vulnérable à ce type de spores. C’est pourquoi le moment de l’inhalation devient un facteur chez une personne en santé car si l’inhalation se fait pendant un moment de faiblesse du système immunitaire, il y aura infection ce qui explique pourquoi Aspergillus est aussi considérée comme une cause de maladie nosocomiale, c’est-à-dire une maladie contractée lors d’un séjour à l’hôpital. De plus, ce mycète est thermorésistant et sa présence est un indicateur d’un milieu malsain comme Stachybotrys, vu ces conditions de croissance.
Voici des photos montrant la vision macroscopique et microscopique d’Aspergillus fumigatus
Comme vous pouvez l’observé, Aspergillus a une forme qu’on peut dire « laineuse ». Les colonies de cette espèce varient entre la couleur bleu-vert à une teinte grise.

Aspergillus fumigatus vu du microscope
Ce mycète est thermo-tolérant et thermophile. Il peut pousser à des températures variant entre 12°C et 57 °C. Il atteindra une croissance optimale dans les températures variant entre 37°C et 43°C. L’humidité doit être relativement élevé pour qu’il y est croissance d’Aspergillus fumigatus tout comme la disponibilité en eau libre. En effet, on parle d’une disponibilité en eau libre entre 0,82 et 0,97.
Elle pourra se développer que si l’activité d’eau libre atteint le 0,9. Ce taux élevé est atteint d’habitude dans les résidences qui ont fait l’objet de dégât d’eau ou qui ont été abandonné, d’où le statut de cette moisissure comme étant un indicateur de milieu malsain si celle-ci parvient à croître. On parle d’un taux élevé à ce chiffre car le maximum d’eau libre possible est de 1.
Finalement, cette moisissure n’est pas très sélective pour ces substrats, donc elle aura de bonne chance de pousser si ces conditions de croissance sont remplies.
Cette deuxième espèce d’Aspergillus est très connue dans le domaine agroalimentaire. C’est un mycète phytopathogène qui s’attaque aux récoltes de maïs et d’arachide.
En effet, il pousse aussi sur les graines, le sol et les dérivés du céréale pour nommer quelques exemples.

Aspergillus flavus sur textiles

Aspergillus flavus prise au microscope optique à 1000X
En plus d’être présent dans la nourriture, il peut aussi être présent dans plusieurs matériaux de construction, tels que le bois, le cuir, les textiles, le papier, les matériaux synthétiques de vernis ou ciré pour en nommer quelques-uns, sans compter qu’on peut le retrouver dans la poussière et les systèmes de ventilation. C’est le 2e plus pathogène des Aspergillus, le 1er étant fumigatus.
Les colonies sont de couleurs vertes-jaunes à vertes olives. Le revers de celle-ci peut être incolore, beige claire, rosâtre à brun-rouge.
Aspergillus flavus est un mycète mésophile pouvant pousser à des températures variant entre 17°C et 48°C. Il atteint une croissance optimale dans les températures variant entre 25°C et 42°C. L’humidité relative doit être entre 80 et 85% et l’activité de l’eau libre, il atteint une croissance optimale entre 0,86 et 0,96, mais il y a d’autres avis qui disent que celle-ci devrait être entre 0,78 et 0,80. On peut voir que ses exigences de croissance sont moins élevées que le fumigatus.
La dernière espèce que nous examinerons plus en détails est cosmopolite et très répandue. Aspergillus niger peut pousser dans le sol, la matière organique et même survivre dans les milieux marins. Pour ce qui est des maisons, elle peut se retrouver sur les matériaux de constructions humides et dans les systèmes de ventilation. Elle n’est vraiment pas discriminateur pour le milieu, tant que les conditions pour sa croissance sont présentes et elle peut se développer sous forte lumière.

Vision macroscopique d’Aspergillus niger

Vision microscopique d’Aspergillus niger
Un lieu où vous ne voulez pas la retrouver est dans le cuir, car elle décompose la fibre interstellaire de celui-ci, lui faisant perde son gras, le rendant plus dur et se faisant, le cuir perd ses propriétés physiques qui le rendent durable. Même si elle n’est pas aussi fameuse pour son pouvoir pathogène que fumigatus, elle reste tout de même un danger pour la santé.
Comme son nom l’indique, les colonies d’Aspergillus niger sont noires, parfois brunes, ce qui peut amener à la confondre avec Stachybotrys chartarum. Pour être en mesure de faire l’identification, il faudra regarder la colonie au microscope afin de confirmer l’identité du genre de moisissure. Certains Penicillium peuvent aussi avoir des colonies noires, ce qui démontre pourquoi il est difficile d’identifier les moisissures à l’œil nu.
De plus, il est bon de savoir que ce n’est pas le seul Aspergillus à avoir des spores noires. A. tubingensis, A. foetidus, A. carbonarius et A. awamor ont tous aussi des spores noires. En effet, il existe d’autres tests une fois que l’on a classé que c’est bien un Aspergillus afin d’identifier l’espèce. Finalement, le mycélium est soit incolore, blanc ou jaune.
Aspergillus niger est aussi un mycète mésophile pouvant pousser à des températures variant entre 20°C et 40°C. Il atteindra une croissance optimale à 37°C. Ensuite, il se développera dans des milieux ayant des activités en eau libre à 0,77.
De plus, on considère cette espèce comme étant xérophile, c’est-à-dire capable de survivre dans des lieux pauvres en eau. Finalement, il est capable aussi de se développer à des humidités relatives variant de 90 à 100 %.
Les risques pour la santé sont semblables pour toutes les espèces d’Aspergillus. Cependant, leur pouvoir pathogène n’est pas le même. Les symptômes principaux liés à ce genre de moisissure sont surtout de nature respiratoire. De plus, il se peut que ces symptômes apparaissent plus tard après l’inhalation étant donné que ce mycète est dit opportuniste, il va attendre un moment de faiblesse du système immunitaires. Il est donc très dangereux pour les personnes ayant des systèmes immunitaires fragiles, tels que les bébés, les personnes âgées, les personnes immuno- déficientes et les personnes ayant des troubles respiratoires au préalable.
Parmi ceux-ci on peut compter les suivants :
L’aspergillose est une maladie pulmonaire provoqué par l’inhalation de spores d’Aspergillus. Ces spores peuvent se rendre très loin dans l’arbre pulmonaire, jusqu’aux alvéoles. Une forte inhalation causera des réactions allergiques, dû aux toxines produites causant la réaction jusqu’à l’élimination. Sinon, on parle de deux types d’aspergillose :
Des trois espèces examinées, A. fumigatus est la plus dangereuse à ce sujet car ces spores sont très volatiles et peuvent pénétrer très loin dans les poumons.
Ensuite, A. Flavus est la deuxième, puisqu’elle peut aussi se rendre loin dans le poumon, mais les spores sont un peu moins volatile. Finalement, Aspergillus niger est l’espèce la moins pathogène des trois vues. Cependant, elle peut tout de même causer des problèmes étant donné qu’elle peut provoquer l’aspergillose du conduit auditif externe chez les sujets présentant une lésion préalable du conduit auditif ce qui peut provoquer des mycoses pulmonaires.
―